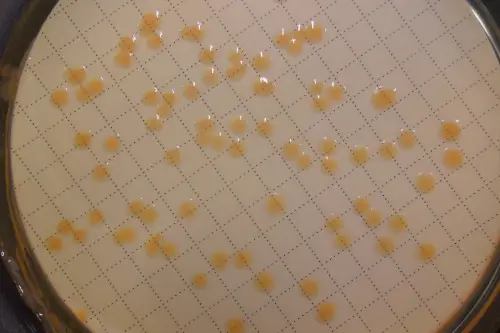
Piastra di Petri con colonie batteriche cresciute su terreno di coltura idoneo (Foto: Agenzia provinciale per l’ambiente e la tutela del clima)
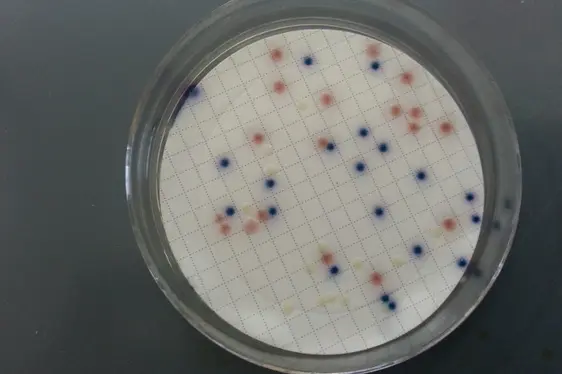
Osservazione e conteggio delle unità formanti colonie (ufc) cresciute dopo incubazione delle piastre (Foto: Agenzia provinciale per l’ambiente e la tutela del clima)

Parametri microbiologici
Il Laboratorio biologico esegue analisi microbiologiche su campioni di acqua per controlli ufficiali. Per “analisi microbiologica di un’acqua” s’intende l'individuazione e il conteggio dei microrganismi presenti in essa.
I parametri microbiologici, in particolare i cosiddetti “batteri indicatori”, assumono grande importanza nella determinazione della qualità delle acque e per definirne la potabilità. La presenza di batteri indicatori (Escherichia coli, batteri coliformi, enterococchi) rivela una contaminazione fecale dell’acqua potabile. Se in un’acqua potabile vengono rilevati questi microrganismi, si presume la presenza anche di microrganismi patogeni (Salmonelle, virus, ecc.). Per questo l’acqua degli acquedotti viene controllata regolarmente, in modo da intervenire tempestivamente per il ripristino della qualità, nel caso di superamento dei limiti previsti dal decreto legislativo 23.02.2023 n. 18 o nel caso si evidenzino situazioni di rischio.
Significato dei parametri microbiologici
I principali parametri microbiologici finalizzati all'individuazione di specie o di gruppi microbici che si ritengono significativi per la formulazione di un giudizio igienico-sanitario o di qualità di un’acqua sono:
Sono diffusi nel suolo, nelle acque e nell'ambiente in generale e parte di loro sono ospiti abituali dell'intestino dell'uomo e degli animali. La loro presenza nelle acque destinate al consumo umano è da mettere in relazione a contaminazione d’origine fecale. Devono essere assenti in 100 ml di campione analizzato.
È una specie batterica termoresistente il cui habitat naturale è l'intestino umano e animale. La sua presenza è un indizio sicuro di contaminazione fecale. Deve essere assente in 100 ml (in 250 ml per le acque imbottigliate) di campione analizzato.
Sono anch'essi ospiti abituali dell'intestino dell'uomo e degli animali e hanno una capacità di sopravvivenza nell’ambiente maggiore rispetto a quella dei Coliformi e di Escherichia coli. La loro presenza indica un possibile inquinamento fecale e devono essere assenti in 100 ml (in 250 ml per le acque imbottigliate) di campione analizzato.
La maggior parte dei clostridi è normalmente saprofita e vive negli strati superficiali del suolo e nei sedimenti, alcune specie vivono nell'intestino di alcuni animali, compreso l’uomo. Sono presenti nelle acque se l'inquinamento non è recente, poiché producono spore termoresistenti e stabili nell'ambiente. Affinché un’acqua sia idonea al consumo umano, questa specie batterica deve essere assente in 100 ml di campione analizzato.
È caratterizzato da un’elevata capacità di adattamento. È un microrganismo prettamente ambientale e, per questo, rilevabile anche in acque potabili, in particolare in condizioni di stagnamento dell’acqua. È in grado di installarsi nei serbatoi, nei rompigetto dei rubinetti e nelle apparecchiature ad uso domestico per il trattamento di acque potabili, raggiungendo cariche batteriche elevate. Deve essere assente in 100 ml (in 250 ml per le acque imbottigliate) di campione analizzato.
Parametro che consente di evidenziare i germi appartenenti alla flora mesofila d’origine umana o animale rilevabili anche negli strati superficiali del terreno.
Parametro che consente di evidenziare le specie microbiche sporigene, cromogene, putrefattive ecc. abbondanti negli strati superficiali del suolo e facilmente adattabili all'ambiente idrico. La presenza di colonie a 22°C dipende dalle caratteristiche intrinseche dell'acqua e non devono essere rilevate variazioni anomale nel tempo.
Analisi microbiologica standard
L'analisi microbiologica standard prevede la ricerca dei seguenti parametri: batteri coliformi, Escherichia coli, enterococchi, colonie a 36°C, colonie a 22°C.
Per crescere velocemente in laboratorio i batteri devono essere coltivati nel cosiddetto “terreno di coltura”, a temperatura adeguata. Il terreno colturale può essere ricco di nutrienti in modo da permettere la crescita di vari tipi di microrganismi (terreno nutritivo), oppure adeguato alle sole esigenze del batterio che si vuole isolare (terreno selettivo).
Il Laboratorio biologico applica metodiche analitiche ufficiali, molte delle quali sono state accreditate da ACCREDIA, l'Ente Italiano di Accreditamento, in conformità alla norma europea UNI CEI EN ISO/IEC 17025.
È possibile visualizzare l’elenco delle prove accreditate da parte di ACCREDIA.